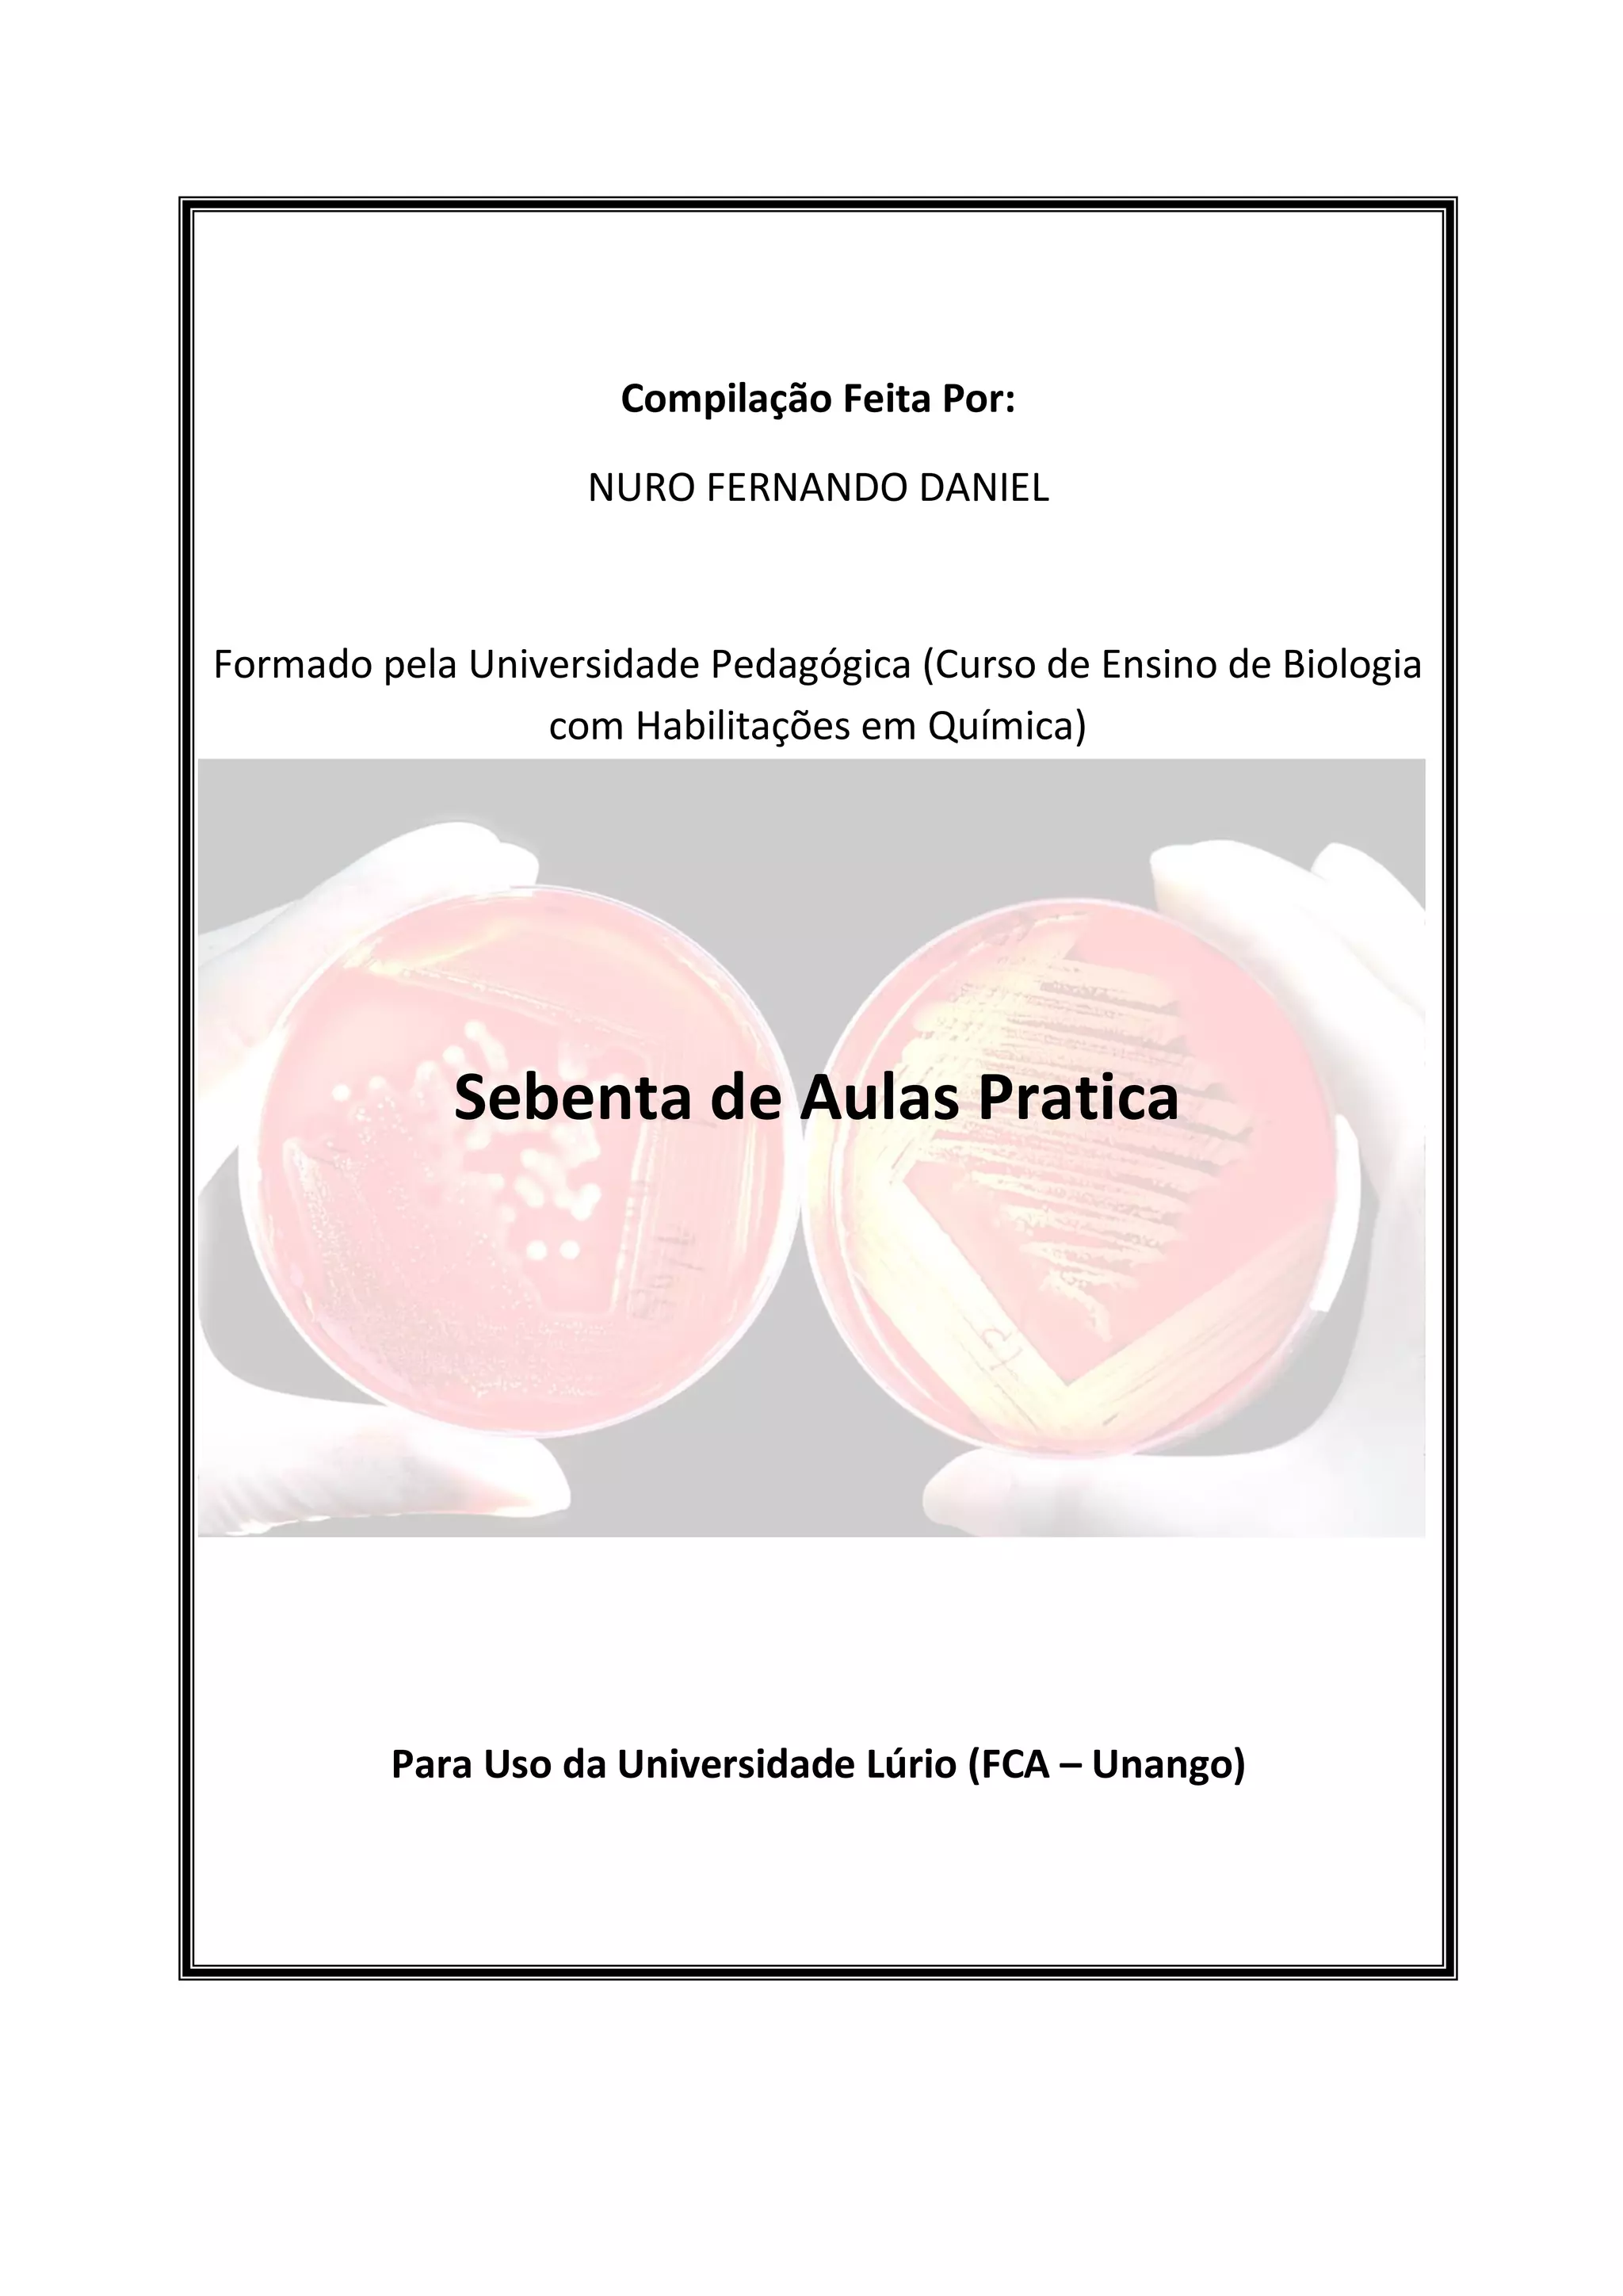

Este documento apresenta vários experimentos e práticas de laboratório para ensinar Biologia, Biologia Celular e Microbiologia. Inclui instruções detalhadas para identificar proteínas, cultivar bactérias, observar a fermentação e construir um terrário de briófitas. O objetivo é fornecer experiências práticas para os alunos aprenderem conceitos biológicos.